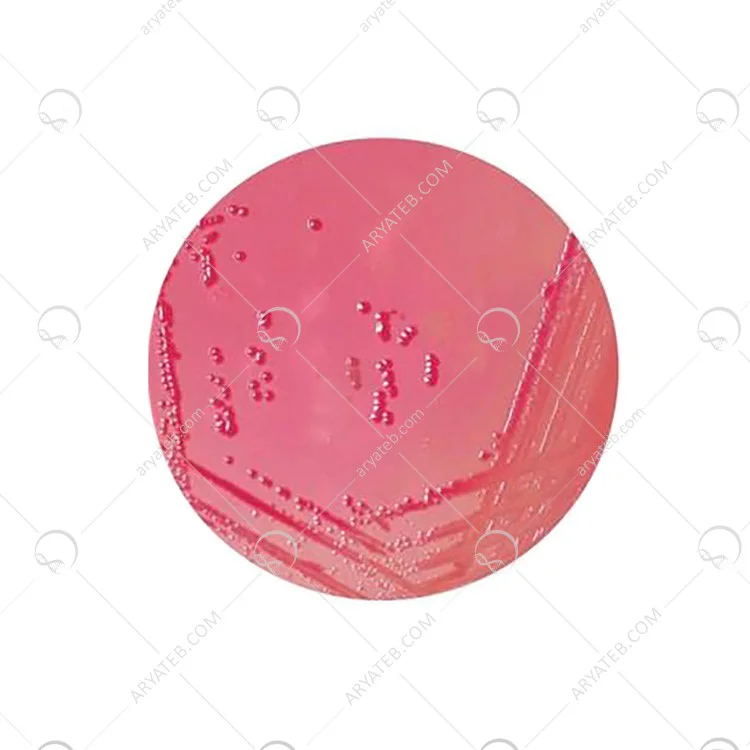

محیط کشت Yersinia selective agar
یرسینیای انتخابی آگار
محیط کشت به محیطی گفته می شود که برای رشد میکروب ها و یا گیاهان بسیار ریز از آن استفاده می کنند. معمولاً محیط کشت دارای ژل و یا مایع می باشد. محیط کشت انواع مختلفی دارد که یکی از انواع آن محیط کشت انتخابی است.
این محیط کشت برای رشد نوع خاصی از میکروب ها و باکتری ها استفاده می شود و از رشد دیگر میکروب ها و باکتری ها در این محیط جلوگیری می شود تا آن نوع خاص میکروب در نظر گرفته به خوبی رشد کند.
اکنون می خواهیم بررسی کنید که محیط کشت یرسینیای انتخابی آگار چگونه می باشد. به طور کلی خوب است بدانید که یرسینیا یک باکتری گرم منفی می باشد. این باکتری گرم منفی از خانواده ی انتروباکتریاسه است.
یرسینیای انتخابی آگار چیست؟
یرسینیای انتخابی اگار برای اولین بار در سال 1979 به وجود آمد. با استفاده از سفسولودین و نووبیوکین برای جداسازی یرسینیای اینتروکولیتیکا در آزمایشگاه استفاده می شود. توجه داشته باشید که برای این جداسازی حتما باید این دو مواد را با هم داشت. یرسینیای انتخابی آگار معمولا برای تشخیص بیماری و یا دیگر شرایط ها در انسان در نظر گرفته نمی شود. یرسینیا اینتروکولیکا یک ماده ی غذایی بسیار مهم و یا آب ناشی از بیماری روده می باشد.
یرسینیای انتخابی آگار یک مکان بسیار خوب و مناسب برای رشد یرسینیای اینتروکولیتیکا می باشد. این محیط به عنوان محیط افتراقی نیز می باشد که می تواند از رشد پشتیبانی کند. یرسینیای انتخابی اگار توسط شیمان گسترش یافته است که معروف به CIN آگار می باشد. این محیط همچنین مبتنی بر فرمول سفسولودین- ایرگاسان- نووبیوکین می باشد.
یرسینیای اگار در مقایسه با دیگر مواد چه فوایدی دارد؟
در مقایسه با مک کانکی اگار و SS اگار، شیمان دریافت که این نوع اگار مهار ارگانیسم های روده طبیعی را افزایش می دهد و بازیابی مستقیم یرسینیای اینتروکولیتیکا را از مدفوع بهبود می بخشد. شیمان بعدها توانست فرمول خود را تغییر و اصلاح کند و به فرمولی دست یابد که بیشتر یرسینیای اینتروکولیکا را رشد دهد و بازیابی ان را بهبود بخشد.
از این یرسینیا برای جداسازی لپتوسپریای spp نیز استفاده می شود. با افزایش مواد غذایی و فلوروراکاسیل 5 می توان میزان آرکوباکتر موجود در گوشت خوک را نشان داد.
خواص محیط کشت یرسینیای انتخابی اگار، براساس مواد شیمیایی انتخابی، انتی بیوتیک ها و رنگ ها و محیط های پایه می باشد. این یرسینیا در برابر رشد باکتری های اشرشیا کولی، کلبسیا پنومونیه، پروتئوس میرابه، سالمونلا اینتریکا، شیگلا سونی و استرپ توکوکاس بسیار انتخاب خوب و به جایی می باشد.
فرمول یرسینیای انتخابی آگار به چه منظور تغییر کرد؟
یرسینیای انتخابی اگار و مکمل های انتخابی SR0109 به طور خاص و چشمگیری برای رشد و بهبود یرسینیای اینتروکولیتیکا در دمای 32 درجه سانتیگراد گسترش پیدا کرده اند. این روند برای یرسینیای اینتروکولیتیکایی است که بعد از 12تا 18 ساعت در دمای 32 درجه ی سانتیگراد تکوین یافته است.
شیمان برای اینکه فرمول قبلی خود را اصلاح کرد، حد متوسطی از نمک های صفراوی را با سدیم دی اسید کلات جایگزین کرد و مقدار غلظت نووبیوکین را از 15 به 2.5 میلی گرم کاهش داد. او این کار را کرد تا مهار کردن برخی از سویه های سروتیپ های 0.8 را از بین ببرد.
از محیط کشت ترمو اسیدورانس برای جداسازی باسیلوس ترمواسیدورانس استفاده می کنند. باسیلوس ترمو اسیدورانس در محصولات غذایی وجود دارد. خوب است بدانید که باسیلوس کواگولانس نام دیگر باسیلوس ترمواسیدورانس است.
باسیلوس کواگولانس معمولاً در خاک وجود دارد و جزء ارگانیسم هایی به حساب می آید که مسئول فاسد شدن غذا های کنسروی می باشد. باسیلوس کواگولانس می تواند در دمای ۲۰ تا ۵۵ درجه سانتیگراد رشد کند و همچنین توانایی رشد در محیط های کشتی که PH ان ۵/۰ تا ۷/۰ است را نیز دارا می باشد.
ترمور اسیدورانس توسط استرن و همکارانش تولید شده است. آنها این محیط را برای جداسازی و همچنین کشت باسیلوس کواگولانس مواد غذایی کنسرو شده توصیه می کنند.
ترکیبات موجود در ترمواسیدورانس چیست؟
پروتئوز پپتون، عصاره مخمر، دی پتاسیم فسفات، دکستروز، آگار و دیگر مواد مغذی ضروری را دارا می باشد. عصاره مخمر و پروتئوز پپتون موجود در محیط کشت ترمواسیدورانس می تواند نیتروژن، کمپلکس ویتامین B و دیگر مواد ضروری برای کشت را به وجود بیاورند. همچنین دی پتاسیم فسفات موجود در این محیط می تواند بافر ضروری و حیاتی را برای محیط کشت فراهم کند. دکستروز نیز همانند یک منبع انرژی برای این محیط کشت به حساب می آید.
نحوه آماده کردن محیط کشت ترمواسیدورانس چگونه است؟
برای اینکه بتوانید این محیط کشت را آماده کنید تا باسیلوس کواگولانس را از محصولات کنسروی جدا کنید باید ۳۹.۲ گرم از این مواد را در یک لیتر آب مقطر بریزید. این محلول را باید روی گرما بگذارید تا بجوشد و به خوبی با هم مخلوط شود.
سپس باید همانند آماده سازی دیگر محیط های کشت آن را در دمای ۱۲۱ درجه سانتیگراد با اتوکلاو استریل کنید و استریل ان باید به مدت ۱۵ دقیقه طول بکشد. بگذارید در دمای ۵۰ درجه سانتیگراد خنک شود و سپس در بشقاب های استریل شده برای آزمایش بریزید.
ممکن است که برای شما سوال پیش بیاید که این محیط کشت را در چه دمایی و چگونه نگهداری کنید. در پاسخ به این سوال باید گفت که ترمواسیدورانس باید در دمای زیر ۸ درجه سانتیگراد نگهداری شود. بهتر است آن را از تابش مستقیم نور آفتاب دور نگه دارید.
این مواد تا زمانی که به محیط کشت تبدیل نشده باشد یک پودر خشکی است که باید در محل خشک و خنک نگهداری شود. بعد از باز کردن درب آن باید آن را محکم ببندید و بهتر است که در دمای ۲ تا ۲۵ درجه سانتیگراد بعد از باز شدن نگهداری شود.
آدرس ایمیل شما منتشر نخواهد شد. فیلدهای الزامی علامت گذاری شده اند *